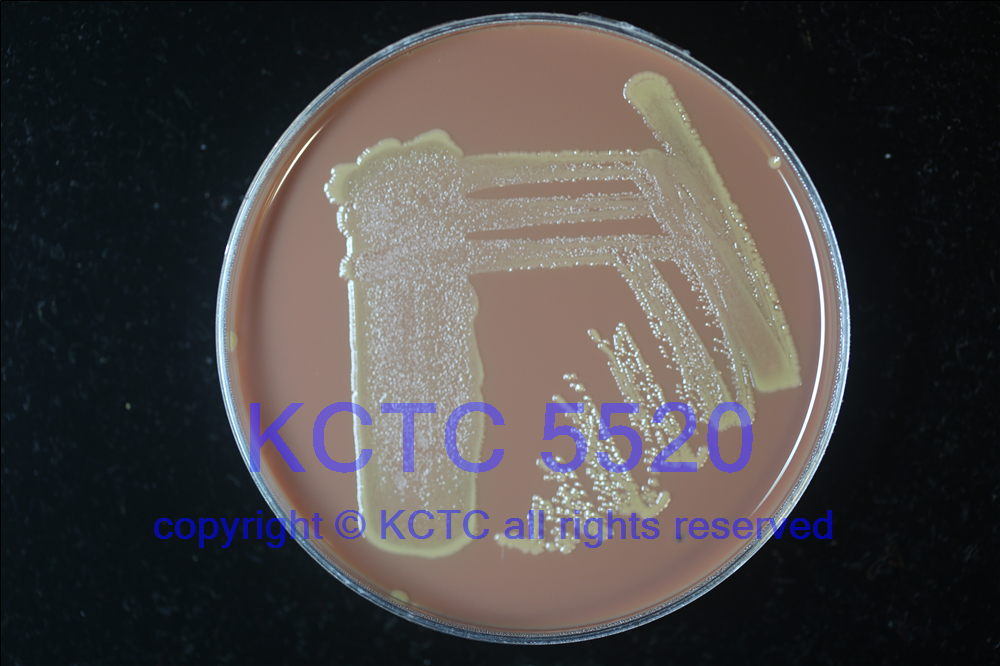

KCTC No. 5520
(KCTC Other No.)
Resource Type Bacteria
Name Neisseria sp.
Type Strain No
Biosafty Level 1
LMO No
Synonym
Phylum (ex Phylum) Pseudomonadota (Proteobacteria - Betaproteobacteria)
Genome Information
History <- Joong-Ki Kook, Chosun Univ., KCOM 1440 <- ChDC B316
Source From subgingival dental plaque, gingivitis, human
Other Collection No. ChDC B316, KCOM 1440
Reference
KCTC Media No. KCTC media No. 753 Blood medium
Oxygen Requirement Facultative Anaerobic
Temperature 37 ℃
pH netural pH ?? ?? (???? ??)
KCTC5520